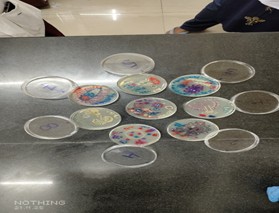
Research Work

Overview of the Department
The Department of Microbiology, Andaman and Nicobar Islands Institute of Medical Sciences (ANIIMS), provides comprehensive Clinical Microbiology laboratory services at GB Pant Hospital along with academic activities conducted within the Microbiology Department. The Clinical Microbiology Laboratory plays a vital role in the diagnosis and identification of infectious disease–causing agents, supporting effective patient management and infection control.
The department is actively involved in teaching Undergraduate Phase II MBBS students as well as Nursing students, with a strong emphasis on both theoretical knowledge and practical laboratory skills. It is fully equipped to deliver reliable and conclusive diagnostic laboratory services while also facilitating high-quality research activities.
The laboratory is dedicated to providing timely and accessible information on current and emerging trends in Microbiology. The department aims to educate and train students in the discipline of Microbiology, foster scientific inquiry, and contribute to the expansion of knowledge in this essential field of medical Sciences.
Department of Microbiology
| S.no | Name | Designation |
|---|---|---|
| 1 | Dr. Ruby Thomas | Professor & Head |
| 2 | Dr. Shwetha V.R | Associate Professor |
| 3 | Dr. Shahina M | Assistant Professor |
| 4 | Dr. Snehaa K | Assistant Professor |
| 5 | Dr. Vineeta | Assistant Professor |
| 6 | Dr. Adrita Das | Senior Resident |
| 7 | Dr. Depti Mitra | Demonstrator |
| 8 | Dr. Anuj Kumar Tiwari | Demonstrator |
| 9 | Dr. Shaniba Rasheed | Demonstrator |
Clinical Microbiology Laboratory
The 2000 square feet state-of-the-art Clinical Microbiology Laboratory caters to patient care by providing comprehensive diagnostic services through multiple sections of Microbiology including Bacteriology, Serology, Parasitology, Mycology, Anaerobic Culture, Mycobacteriology, and Molecular Diagnostics. This Biosafety Level–2 (BSL-2) laboratory is equipped with both conventional and advanced automated diagnostic systems.
The laboratory facilities include automated blood culture systems (BD BACTEC FX40), automated culture identification and antimicrobial susceptibility testing (BD Phoenix), microscopy using direct and fluorescent microscopes, and serological testing through ELISA and Chemiluminescence assays. Molecular diagnostic tools are also utilized for end-point diagnosis of selected common infectious diseases of public health importance.
The department plays a crucial role in continuous surveillance of locally prevalent infectious diseases with epidemic potential and provides diagnostic support to the Integrated Disease Surveillance Programme (IDSP). The Clinical Microbiology Laboratory serves the islands by delivering a wide range of laboratory services while maintaining excellence in teaching and research activities.
Annual Workload Summary (2024–2025)
| Microbiology Section | Total Number of Tests Done |
|---|---|
| Bacteriology | 11,360 |
| Virology & Serology | 67,644 |
| Mycology | 584 |
| Parasitology | 1,832 |
| Mycobacteriology (Extra-pulmonary & AFB Smear) | 8,491 |
| Total Tests (2024–2025) | 89,911 |
Antimicrobial Resistance (AMR) Surveillance
The Clinical Microbiology Laboratory is enrolled in the National Antimicrobial Resistance (AMR) Surveillance Network of State Medical Colleges coordinated by the National Centre for Disease Control (NCDC) since 2023. The laboratory generates high-quality AMR data on seven priority pathogens of public health importance, which is entered into the WHONET software and submitted to NCDC, Delhi on a monthly basis.
In addition, quarterly compiled AMR data along with resistant organism isolates are sent to NCDC as per the Standard Operating Procedure manual for proficiency testing and validation.
AMR Surveillance Summary
| Specimen Type | IPD | OPD | ICU | Total Specimens | Total Positive | AMR Priority Pathogens Isolated |
|---|---|---|---|---|---|---|
| Urine | 1295 (29.09%) | 2976 (66.86%) | 180 (4.04%) | 4451 | 967 (21.7%) | 810 (83.76%) |
| Blood | 1155 (45.83%) | 264 (10.47%) | 1101 (43.69%) | 2520 | 410 (16.26%) | 153 (37.31%) |
| Stool | 25 (6.26%) | 374 (93.73%) | 0 (0%) | 399 | 0 (0%) | 0 (0%) |
| Pus Aspirate | 829 (46.65%) | 848 (47.72%) | 100 (5.62%) | 1777 | 1061 (59.70%) | 798 (75.21%) |
| Other Body Fluids | 129 (70.49%) | 6 (3.27%) | 48 (26.22%) | 183 | 24 (13.11%) | 18 (75%) |
| Total | 3433 (36.79%) | 4468 (47.88%) | 1429 (15.31%) | 9330 | 2462 (26.38%) | 1780 (72.29%) |
Proficiency Testing (EQAS)
The Clinical Microbiology Laboratory is enrolled in the External Quality Assurance Programme (EQAS) with CMC Vellore for Bacteriology and Serology sections since January 2024. Proficiency testing is conducted quarterly to ensure generation of accurate and reliable laboratory reports.
Additionally, EQAS samples for Bacteriology isolates are sent quarterly to NCDC, Delhi.
| Section | Panel 1 (2024) | Panel 2 (2024) | Panel 3 (2024) | Panel 1 (2025) | Panel 2 (2025) |
|---|---|---|---|---|---|
| Bacteriology – Identification & AST | 94% | 89.1% | 91.8% | 100% | 96.9% |
| Serology – Blood Borne Viruses | 100% | 100% | 100% | 100% | 100% |
Hospital Infection Control
The Hospital Infection Control Committee (HICC), ANIIMS actively oversees infection prevention and control activities. Regular meetings are conducted to review infection control policies, healthcare-associated infection surveillance, and compliance with standard precautions.
The committee emphasizes hand hygiene, biomedical waste management, environmental sanitation, and rational use of personal protective equipment. Faculty members are involved in training healthcare workers through lectures, demonstrations, and regular modules on infection control and biomedical waste management.
HICC Meetings – 2025
- 1st Quarter – 17.01.2025
- 2nd Quarter – 04.04.2025
- 3rd Quarter – 04.07.2025, 11.08.2025, 29.08.2025
- 4th Quarter – 04.11.2025
Molecular & Research Laboratory
The Department has commissioned a Molecular Microbiology Laboratory, which is a Biosafety Level–2 (BSL-2) facility equipped with advanced instruments including Automated RNA/DNA Extractor, Real-Time PCR, Truenat Machine, and other essential equipment for molecular diagnostics and research.
The Research Laboratory supports faculty and students in institutional and collaborative research by providing essential laboratory facilities and technical support. The laboratory adheres strictly to biosafety and ethical standards while promoting a strong research culture within the institute.
Undergraduate Teaching
The academic activities of the Department of Microbiology include teaching–learning programs for Undergraduate Phase II MBBS students and Nursing undergraduate students. Teaching activities are conducted in the Demonstration Room, Museum, Practical Hall, and a separate preparation room, all of which are well-equipped with the necessary instruments and facilities.
The Competency Based Medical Education (CBME) pattern has been incorporated as per NMC guidelines, providing students ample opportunity to clarify subject-related queries. Teaching methodologies include class assignments, small group discussions (SGD), self-directed learning (SDL), practical classes, and continuous assessment of skill-based competencies throughout the year.
Workshops, Conferences & CMEs
Dr. Ruby Thomas
- Regional Training on Airborne Infection Control (AIC), CTD–FIND India, Coimbatore, Jan 22–23, 2025.
- World TB Day participation, DHS & UT Health Mission, A&N Administration, 24 March 2025.
- Workshop on World Sickle Cell Day, RMRC–ICMR, SVP, 19 June 2025.
- Workshop on Medsim 2.0 – AIIMS Bhubaneswar, 30 Sept 2025.
- CME on Antimicrobial Resistance – Ruxmaniben Deepchand Gardi Medical College, 8 Nov 2025.
- Symposium – Bridging the Gap: From AMR Data to Clinical Practice, ANIIMS, 24 Nov 2025.
Dr. Shwetha V R
- World TB Day participation – 24 March 2025.
- Workshop on Medsim 2.0 – AIIMS Bhubaneswar, 30 Sept 2025.
- Symposium – Bridging the Gap: AMR Data to Clinical Practice, ANIIMS, 24 Nov 2025.
Dr. K. Snehaa
- National Workshop on Antimicrobial Stewardship, AIIMS Mangalagiri, Jan 7–11, 2025.
- World Sickle Cell Day Workshop, RMRC–ICMR, 19 June 2025.
- Training on Airborne Infection Control, ANIIMS, 4 Nov 2025.
- Symposium – AMR Data to Clinical Practice, ANIIMS, 24 Nov 2025.
Dr. Vineeta
- John Hopkins Infectious Disease Programme, Chennai, Feb–Mar 2025.
- ICARE Program (BIHER accredited), Feb–Apr 2025.
- Global Grand Rounds in Infectious Disease – John Hopkins, Online.
- Basic Course in Medical Education, ANIIMS, Apr 2025.
- Training on Airborne Infection Control, ANIIMS, Nov 2025.
Institutional Committee Memberships
- Dr. Ruby Thomas: Member Secretary – HICC, Chairperson – Procurement, Grievance & ICC, Lab Director SRL (NACO), Curriculum Committee.
- Dr. Shwetha V R: Nodal Officer – One Health Programme, MEU Member, Student Affairs Chairperson.
- Dr. K. Snehaa: Nodal Officer – AMR Surveillance, Infection Control Officer, Phase II Coordinator.
- Dr. Vineeta: Store Committee Member, Link Officer – Intern Hostel.
Ongoing & Completed Projects
- Dr. Ruby Thomas: Biofilm-producing Acinetobacter study; Pediatric bloodstream infections (ICMR STS – Ongoing).
- Dr. Shwetha V R: Antimicrobial stewardship education (Completed); AI in medical education; GBS screening & CRE studies (Ongoing).
- Dr. K. Snehaa: Hand hygiene compliance; Vancomycin-resistant Staphylococcus aureus studies (Ongoing).
- Dr. Vineeta: Colistin resistance detection in CRE & CRPA (Ongoing).
Publications
- Snehaa K et al. Surgical Site Infections – J West Afr Coll Surg, 2025.
- Damodharan P et al. Next-generation vaccines against AMR – Indian Journal of Medical Microbiology.
- Gracia J et al. Drug repurposing against Streptococcus pyogenes – Int J Biological Macromolecules.
Microbiology Department Gallery